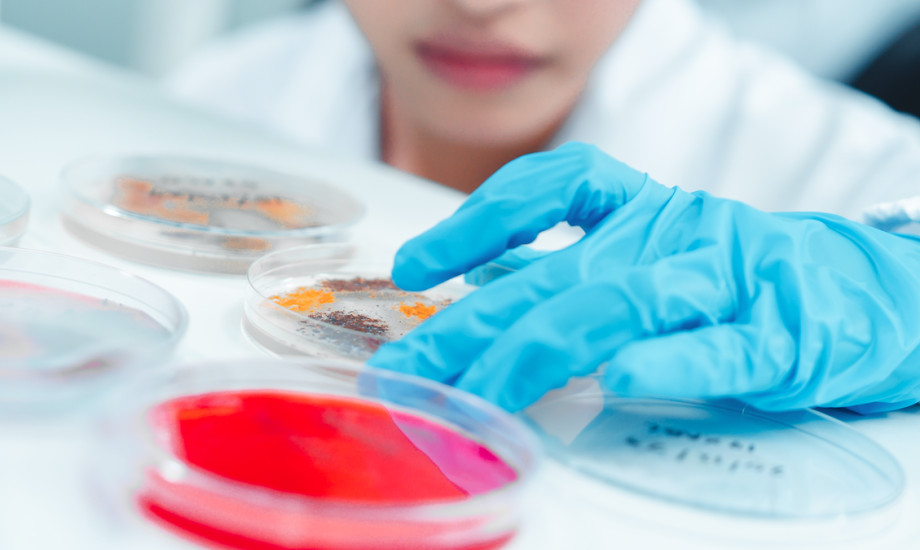

Fachgesellschaften sehen infektiologische Versorgung in Gefahr
Die „Klinische Infektiologie“ soll keine eigene Leistungsgruppe mehr darstellen, so sieht es der Entwurf für ein Gesetz zur Anpassung der Krankenhausreform vor. Zahlreiche Fachgesellschaften und Verbände kritisieren die Streichung dieser Leistungsgruppe nun als „gravierende gesundheitspolitische Fehlentscheidung“.